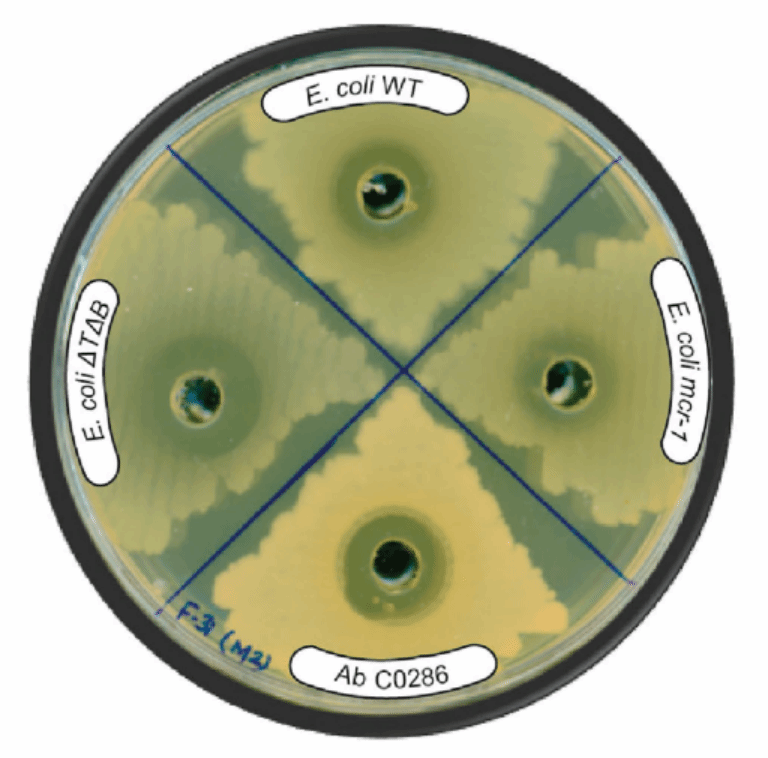

自20世纪40年代青霉素问世以来,抗生素一直是人类对抗细菌感染的利器。然而,随着时间的推移,越来越多的细菌学会了反制这些药物,演变出复杂的耐药机制。今天,抗生素耐药性已成为全球公共卫生面临的严峻危机。根据《柳叶刀》的系统评估,2019年全球已有超过450万人因耐药微生物感染死亡。
更令人忧心的是,自20世纪90年代以来,我们再未迎来一种全新机制的抗生素上市。医学界陷入“药物开发停滞—耐药性加剧”的境地。
2025年,一支来自加拿大麦克马斯特大学的研究团队从普通的后院泥土中,分离出一种名为拉里欧菌素(Lariocidin)的新型抗生素。这不是对旧药的改造,而是一种结构新颖、机制独特、对耐药菌有效的新品种。

发表在《自然》杂志上发现新抗生素的研究(图片来源:参考文献[1])
耐药危机——我们为何急需新抗生素?
抗生素的成功曾一度让人类相信,细菌感染不再是威胁。然而事实并非如此乐观。随着抗生素使用越广泛,细菌进化得就越迅速。它们通过突变等手段,逐步学会了如何抵抗抗生素的攻击。这种抗药性的广泛传播,使得一些原本可控的感染变得无药可用。
这一现象被世界卫生组织称为抗生素耐药性(Anti-microbial Resistance,AMR),已被列为全球十大公共卫生威胁之一。AMR带来的危害不只是感染难治,它还威胁到器官移植、癌症化疗、外科手术等对无菌环境高度依赖的现代医疗手段。无数曾被认为是低风险的疾病和手术,正因抗生素失效而重新变得危险。
更令人担忧的是,新抗生素的研发速度远远赶不上耐药性的扩散。过去30年,上市的新型抗生素几乎都是现有药物的小幅改良,缺乏结构和机制的根本突破。尤其在对抗革兰氏阴性菌方面,几乎没有新的抗生素处于研发阶段。
在这样的背景下,任何一种真正新机制的抗生素,都具有里程碑式的意义。拉里欧菌素(Lariocidin)正是在这种压力下诞生的:它不仅拥有独特的分子结构,还能以前所未有的方式攻击细菌的生命核心——核糖体。
Lariocidin 是什么?它从哪里来?
科学的突破,往往并非来自遥远的高科技实验室,而可能就隐藏在你我脚下的泥土中,拉里欧菌素(Lariocidin)的就来自于泥土的新型抗生素。
这项发现源自加拿大安大略省汉密尔顿市的一把泥土。研究团队由麦克马斯特大学的抗感染专家Gerry Wright教授领导,他们对收集到的土壤样本进行了为期一年的低温慢培养,目的是激发那些在传统实验条件下难以生长的微生物。正是在这个过程中,他们从一个名为 Paenibacillus sp. M2 的土壤细菌中,分离出一种从未见过的抗菌活性物质。

拉里欧菌素来自泥土(图片来源:作者使用AI生成)
经结构鉴定与基因分析,这种物质被命名为拉里欧菌素(Lariocidin),属于一种高度独特的套索肽(lasso peptide)。这类分子得名于其奇特的打结三维结构:一端的肽链像套索一样从一个内环穿过,构成高度稳定的结形分子构型。这种结构不仅赋予其极强的热稳定性和酶降解抗性,也使它具备了独特的药理活性。

一种套索肽结构(图片来源:参考文献[3])
更令人惊喜的是,研究人员还发现了Lariocidin的两个天然变体:LAR-B 和 LAR-C,其中LAR-B由于形成了第二个内打结的结构也就是双套索结构,被认为可能代表一种全新的第五类套索肽结构。这些化学结构的多样性为未来抗生素的优化设计提供了丰富的模板。

结合核糖体的 LAR 和 LAR-B 的结构与电子密度图(图片来源:参考文献[1])
拉里欧菌素并不是微生物为了人类而设计的。在自然界中,它可能是 Paenibacillus 用来与其他细菌竞争的一种生化武器。
一种前所未见的作用机制杀死细菌
抗生素的杀菌原理多种多样,常见的包括青霉素破坏细胞壁、喹诺酮类干扰DNA复制、四环素阻断蛋白质合成。而拉里欧菌素(Lariocidin)则以一种全新的方式干扰细菌的蛋白合成机器——核糖体,成为首个以独特方式作用于核糖体小亚基的套索肽类抗生素。
Lariocidin对鲍曼不动杆菌以及大肠杆BW25113菌株的抗菌活性(图片来源:参考文献[1])
核糖体是细菌制造蛋白质的核心工厂,所有维持生命的酶和结构蛋白都依赖它。通过结构分析显示,拉里欧菌素直接结合在核糖体30S小亚基靠近解码中心的位置——这是核糖体识别和读取mRNA密码的关键区域。
与多数抗生素不同,Lariocidin并不是阻止tRNA进入核糖体,而是锁定核糖体的运动机构。在正常翻译过程中,mRNA和tRNA需在核糖体内精确地前后移动,由伸长因子EF-G驱动完成。Lariocidin 正是通过结合核糖体的头部与肩部区域,抑制了这一关键的转位步骤,导致蛋白质合成陷入停顿。
更令人惊讶的是,Lariocidin 不仅让核糖体停工,还会让它出错。在实验中,科学家发现它能促使细菌核糖体读错密码子,导致合成出功能异常的蛋白质。
这种“双重打击”机制——既阻断蛋白合成,又诱导错误翻译,是目前所有已知套索肽中前所未有的。
动物实验证明了Lariocidin 的治疗潜力
在抗生素研究中,从体外实验到动物模型是迈向临床应用的关键一步。Lariocidin不仅在实验室中显示出对多种致病菌的显著抑制作用,还在小鼠感染模型中展现了极具前景的治疗潜力。
研究人员选取了临床最难治的病原之一——耐药鲍曼不动杆菌(Acinetobacter baumannii)作为感染模型。在构建的中性粒细胞缺乏型小鼠模型中(模拟免疫抑制状态),感染组在28小时内全部死亡。而接受Lariocidin治疗的实验组小鼠,不仅全部存活超过48小时,而且细菌负载在血液、肌肉和脾脏中显著下降——细菌数量降低近百倍。
在营养缺乏等模拟真实感染环境的培养条件下,Lariocidin 对多种临床病原体的抑菌浓度(MIC)显著降低,例如对多重耐药大肠杆菌、耐甲氧西林金黄色葡萄球菌(MRSA)和结核分枝杆菌都有良好抑制效果。同时,它几乎不受现有抗药机制影响,并且产生耐药突变的频率极低(约10⁻⁸),说明它的“打击方式”对细菌来说难以应对。
实验显示,Lariocidin 在人类肾细胞(HEK293)中无显著毒性,浓度高达1000 μg/mL时仍无抑制作用。它也不会影响人体内常见的有益肠道细菌,如双歧杆菌和乳酸杆菌等。
总结
拉里欧菌素的发现不仅是一种新型抗生素的诞生,更是一种全新抗菌机制的突破。它打破了传统抗生素“靠老药改良”的困境,以套索肽独特的结构锁定细菌核糖体的新位点,在对抗耐药菌方面展现出前所未有的潜力。它的低毒性、高选择性和良好体内疗效,让人们再次看到了战胜“超级细菌”的希望。
作者:Denovo科普团队(褚宏伟 博士、湖南师范大学硕士生导师;杨超 博士)
审核:刘晨光 博士、大连理工大学教授
参考文献:
[1] Jangra, Manoj, et al. "A broad-spectrum lasso peptide antibiotic targeting the bacterial ribosome." Nature (2025): 1-9.
[2] Murray, Christopher JL, et al. "Global burden of bacterial antimicrobial resistance in 2019: a systematic analysis." The lancet 399.10325 (2022): 629-655.
[3] Hegemann, Julian D., et al. "Lasso peptides: an intriguing class of bacterial natural products." Accounts of chemical research 48.7 (2015): 1909-1919.
[4] Willyard, Cassandra. "The drug-resistant bacteria that pose the greatest health threats." (2017): 15-15.